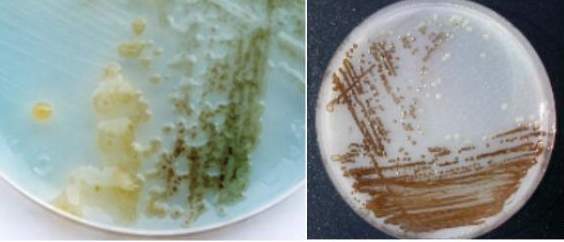

BIOCONVERSIONE DI REFLUI OLEARI MEDIANTE FERMENTAZIONE AEROBICA E COMPOSTAGGIO
Lucia Aquilanti (a), Andrea Osimani (a), Manuela Taccari (a), Cristiana Garofalo (a), Maurizio Ciani (b), Massimo Mozzon (a), Francesca Clementi (a)
a Dipartimento di Scienze Agrarie, Alimentari ed Ambientali (D3A) e b Dipartimento di Scienze della Vita e dell’Ambiente (DiSVA), Università Politecnica delle Marche, Ancona, Italia
L’Italia è tra i maggiori paesi produttori al mondo di olio d’oliva, insieme alla Spagna e alla Grecia. L’estrazione di olio d’oliva è principalmente eseguita tramite sistemi tecnologici che operano in modo discontinuo (pressatura) o continuo (centrifugazione); tali sistemi producono sia residui solidi (sanse) che liquidi (acque reflue di vegetazione) (Otles e Selek, 2012). Le acque reflue di vegetazione sono caratterizzate da un elevato contenuto di sali inorganici, principalmente fosfati, e materia organica (Chemical Oxigen Demand-COD, 50-150 g L-1) costituita da composti azotati, acidi organici, zuccheri, tannini, pectine, carotenoidi, residui di olio e sostanze fenoliche (Piperidou et al., 2000;. Mekki et al., 2006;. Piotrowska et al., 2006; Anastasiou et al., 2011).
Negli ultimi decenni, il notevole aumento della produzione di olio d’oliva ha reso lo smaltimento e il trattamento delle acque di vegetazione un serio problema per l’industria olearia (Rozzi e Malpei, 1996). La strategia più semplice ed economica per la gestione e lo smaltimento di questo sottoprodotto consiste nella diffusione controllata in terra delle acque di vegetazione non trattate (Otles e Selek, 2012); tuttavia, l’applicazione diretta di acque di vegetazione sui terreni agricoli apporta sia effetti positivi che negativi, quest’ultimi principalmente attribuibili all’alto contenuto di sali minerali, al basso pH, e alla grande abbondanza di composti con attività fitotossica e antimicrobica (Otles e Selek, 2012). Di conseguenza, sono state proposte diverse strategie di tipo fisico, fisico-chimico e biologico che consentano il trattamento delle acque di vegetazione (Otles e Selek, 2012); tra queste, alcuni processi biologi, come i trattamenti aerobici con microrganismi selezionati e il compostaggio, sono poco dispendiosi dal punto di vista economico e certamente a basso impatto ambientale (Mantzavinos e Kalogerakis, 2005).
I trattamenti aerobici sono rivolti principalmente a degradare una frazione degli inquinanti delle acque di vegetazione attraverso un processo ossidativo; fino ad oggi è stato testato un certo numero di microrganismi, utilizzati in coltura pura o in pool; fra questi, alcune specie appartenenti ai generi Arthrobacter, Sphingomonas, Ralstonia, Bacillus, Pseudomonas, ed Azotobacter (Knupp et al., 1996; Ramos-Cormenzana et al., 1996.; Ehaliotis et al., 1999; Di Gioia et al., 2001; Niaounakis e Halvadakis, 2006). In particolare, il genere Azotobacter include batteri azoto-fissatori liberi, diffusi sia in terreni neutri che alcalini, acqua e sedimenti. A causa del basso contenuto in composti organici azotati e la ricchezza di fonti di carbonio, le acque di vegetazione risultano essere un substrato ideale per la crescita dei batteri azotofissatori. A tal riguardo, alcuni studi hanno ampiamente dimostrato come isolati di Azotobacter chroococcum e Azotobacter vinelandii siano capaci di svilupparsi attivamente (García Barrionuevo et al., 1992; Aquilanti et al., 2014) e di fissare l’azoto atmosferico (Balis et al., 1996; Papadelli et al., 1996) in acque di vegetazione sterili non diluite ed entrambe le specie hanno mostrato la capacità di utilizzare composti aromatici come fonte carbonio e di energia (Anastasiou et al., 2011). Per A. vinelandii, è stata inoltre dimostrata anche la capacità di produrre metaboliti promotori di fertilità del suolo (Fiorelli et al., 1996) ed esopolisaccaridi (Niaounakis e Halvadakis, 2006) in acque di vegetazione diluite. In Grecia, un isolato di A. vinelandii (ceppo A) è stato sfruttato in un impianto pilota per il trattamento aerobico delle acque di vegetazione, con risultati molto promettenti in termini di rimozione di composti fitotossici (Piperidou et al., 2000).
Il compostaggio rappresenta una ulteriore utile strategia per lo smaltimento delle acque di vegetazione; tale metodica consente il riciclaggio di sostanza organica attraverso l’attività della microflora endogena della matrice compostata (Hachicha et al., 2008). Grazie al suo elevato contenuto in carbonio e sostanze umiche, il compost ha una elevata attività fertilizzante (Hachicha et al., 2008). Esiste attualmente una notevole bibliografia sul compostaggio delle acque vegetazione (Hachicha et al., 2008; Aviani et al., 2010; Cayuela et al., 2010; Altieri et al., 2011.; Federici et al., 2011; Taccari et al., 2009; Taccari et al., 2011; Aquilanti et al., 2014) e sono disponibili prove scientifiche sulla capacità fertilizzante del compost ottenuto da tali reflui (Mantzavinos e Kalogerakis, 2005; Taccari et al., 2009; Taccari et al., 2011; Aquilanti et al., 2014); tuttavia, sono attualmente disponibili pochi dati sull’applicazione delle acque di vegetazione durante il compostaggio prolungato (superiore a 4 mesi) (Hachicha et al., 2008; Aquilanti et al., 2011).
Uno studio di Taccari e collaboratori (2009) ha recentemente esaminato il processo di co-compostaggio combinando acque di vegetazione ottenute a seguito di diversi sistemi di estrazione dell’olio d’oliva con vari rifiuti agricoli. In tale studio sono stati valutati gli effetti dell’utilizzo di inoculi di eumiceti, in particolare Phanerochaete chrysosporium, durante la fase di maturazione al fine di ridurre la tossicità delle acque di vegetazione e migliorare il grado di maturazione dei substrati risultanti. I risultati di tale studio hanno mostrato riduzioni importanti nella quantità di fenoli solubili; inoltre, sono stati osservati miglioramenti in merito alle attività microbiche e alla riduzione dei fenoli solubili quando l’acqua di vegetazione è stato mescolata a residui di trinciature.
Durante la maturazione del compost, l’inoculo di P. chrysosporium ha determinato sia la degradazione dei fenoli solubili nelle acqua di vegetazione, che e il rilascio di sostanze fenoliche idrosolubili, con una consistente riduzione della fitotossicità dopo 36 giorni di colonizzazione del compost. Gli stessi Autori hanno concluso che P. chrysosporium può essere utilizzato con successo durante la maturazione del compost con miscele di acque di vegetazione e rifiuti agricoli (ricchi di composti lignocellulosici), così come per migliorare la maturità del compost e ridurne gli effetti fitotossici.
Lo stesso gruppo di ricerca (Taccari et al. 2011) ha studiato la capacità di alcuni lieviti (Pichia fermentans e Candida spp.) di ridurre il contenuto in composti fenolici e la citotossicità di acque di vegetazione non diluite, sostenendo che tali microrganismi risultano essere buoni candidati per la detossificazione di acque di vegetazione stoccate. Lo studio ha infatti verificato la capacità di sviluppo di tali microrganismi in acque di vegetazione stoccate senza alcuna aggiunta di nutrienti. Le acque di vegetazione possono essere considerate un mezzo di crescita utile per varie applicazioni biotecnologiche che prevedano l’utilizzo di eumiceti per la produzione di metaboliti e/o biotrattamenti, volte a migliorarne le caratteristiche come potenziale fertilizzante. Tuttavia, sono necessarie ulteriori indagini per ottimizzare le prestazioni dei ceppi di lieviti selezionati e per valutare la reale possibilità di utilizzare la biomassa ottenuta per l’alimentazione animale.
Un recente studio di Aquilanti e collaboratori (2014) ha preso in considerazione l’utilizzo di un approccio integrato basato sul pretrattamento aerobico di acque di vegetazione aggiunte di calce con azotofissatori liberi (Fig. 1) seguita da compostaggio di paglia trinciata. Il pretrattamento aerobico è stato eseguito in fermentatori di laboratorio utilizzando un consorzio di batteri opportunamente selezionati per la loro capacità di abbattere (e quindi indirettamente metabolizzare) i polifenoli; il biofermentato ottenuto (con ridotta attività antimicrobica) è stato successivamente applicato a cumuli di trinciato di paglia, all’inizio del processo di compostaggio. Nello studio è stato inoltre valutato l’effetto (in termini di diminuzione del contenuto in polifenoli totali) della applicazione regolare di acque di vegetazione ai cumuli durante il compostaggio prolungato (136 giorni).
Figura 1. Colture di azotofissatori liberi (Azotobacter chroococcum) utilizzate per la produzione di un biofermentato di acque di vegetazione pretrattate con calce, impiegato in prove di compostaggio di cumuli di paglia trinciata, su scala di laboratorio.

Figura 2. Cumuli (5 Kg) di trinciato di paglia inoculati con il biofermentato di acque di vegetazione, in prove di compostaggio su scala di laboratorio.
I risultati preliminari ottenuti in questo studio hanno dimostrato che l’approccio integrato proposto può essere efficacemente utilizzato per il biorisanamento di acque di vegetazione, al fine di ottenere un concime organico utilizzabile per il miglioramento dei terreni agricoli. La fermentazione aerobica di acque di vegetazione pre-trattate con calce da parte del consorzio batterico ha prodotto una detossificazione e una riduzione dell’attività antimicrobica e in concomitanza un arricchimento con microrganismi benefici. Inoltre, l’aggiunta iniziale del biofermentato a cumuli di compost regolarmente addizionati di acque di vegetazione ha mostrato un impatto positivo sulla qualità del compost finale, in termini di stabilità del compost.
Prospettive future di Ricerca
Al fine di confermare le evidenze sperimentali emerse nel corso degli studi sopradescritti, appare utile realizzare prove di compostaggio, su scala pilota, con cumuli di trinciato di paglia e cippato di legno, periodicamente irrorati con acque di vegetazione ed inoculati con colture selezionate di (i) azotofissatori liberi; (ii) eumiceti; (iii) un pool dei due precedenti gruppi microbici. Nel corso delle prove di compostaggio, si prevede di effettuare i seguenti rilievi analitici su acque di vegetazione e/o cumuli: (i) monitoraggio dell’attività microbiologica attraverso test S.O.U.R. (Specific Oxygen Uptake Rate) (Taccari et al.,2011; 2009); (ii) determinazione del contenuto in sostanza organica totale (COD); (iii) determinazione del contenuto in polifenoli totali; (iv) monitoraggio della temperatura; (v) enumerazione di microrganismi azotofissatori liberi nel corso del processo di compostaggio, e verifica dell’effettiva colonizzazione dei cumuli da parte dei ceppi inoculati e/o residenti; (vi) enumerazione di eumiceti cellulosolitici, e verifica dell’effettiva colonizzazione dei cumuli da parte dei ceppi inoculati e/o residenti; (vii) monitoraggio delle dinamiche microbiche (sia batteriche sia eumicetiche), tramite indagini biomolecolari (es. PCR-DGGE) per l’identificazione delle specie dominanti; (viii) prove di germinabilità e fitotossicità (su compost maturo); (ix) determinazione del contenuto in azoto solubile/azoto totale (su compost maturo).
Bibliografia
Altieri, R., Esposito, A., Nair, T., 2011. Novel static composting method for bioremediation of olive mill waste. Int. Biodeterior. Biodegrad. 65, 786-789.
Anastasiou, C.C., Christou, P., Michael, A., Nicolaides, D., Lambrou, T.P., 2011. Approaches to olive mill wastewater treatment and disposal in Cyprus. Environ. Res. J. 5, 49-58.
Aquilanti, L., Taccari, M., Bruglieri, D., Osimani, A., Clementi, F., Comitini, F., Ciani, M., 2014. Integrated biological approaches for olive mill wastewater treatment and agricultural exploitation. Int. Biodet. Biodegrad. 88, 162-168.
Aviani, I., Laor, Y., Medina, S., Krassnovsky, A., Raviv, M., 2010. Co-composting of solid and liquid olive mill wastes: management aspects and the horticultural value of the resulting composts. Bioresour. Technol. 101, 6699-6706.
Balis, C., Chatzipavlidis, J., Flouri, F., 1996. Olive mill waste as a substrate for nitrogen fixation. Int. Biodeterior. Biodegrad. 38, 169-178.
Cayuela, M.L., Sanchez-Monedero, M.A., Roig, A., 2010. Two-phase olive mill waste composting: enhancement of the composting rate and compost quality by grape stalks addition. Biodegradation 21, 465-473.
Di Gioia, D., Bertin, L., Fava, F., Marchetti, L., 2001. Biodegradation of hydroxylated and methoxylated benzoic, phenylacetic and phenylpropenoic acids present in olive mill wastewater by two bacterial strains. Res. Microbiol. 152, 83-93.
Ehaliotis, C., Papadopoulou, K., Kotsou, M., Mari, I., Balis, C., 1999. Adaptation and population dynamics of Azobacter vinelandii during aerobic biological treatment of olive-mill wastewater FEMS Microbiol. Ecol. 30, 301-311.
Federici, E., Pepi,M., Esposito, A., Scargetta, S., Fidati, L.,Gasperini, S., Cenci, G., Altieri, R., 2011. Two-phase olive mill waste composting: community dynamics and functional role of the resident microbiota. Bioresour. Technol. 102, 10965-10972.
Fiorelli, F., Pasetti, L., Galli, E., 1996. Fertility-promoting metabolites produced by Azotobacter vinelandii grown on olive-mill wastewaters. Int. Biodeterior. Biodegrad. 38, 165-167.
García-Barrionuevo, A., Moreno, E., Quevedo-Sarmiento, J., Gonzalez-Lopez, J., Ramos-Cormenzana, A., 1992. Effect of wastewaters from olive oil mills (alpechin) on Azobacter nitrogen fixation in soil. Soil. Biol. Biochem. 24, 281-283.
Hachicha, S., Sallemi, F., Medhioub, K., Hachicha, R., Ammar, E., 2008. Quality assessment of composts prepared with olive mill wastewater and agricultural wastes. Waste Manag. 28, 2593-2603.
Knupp, G., Rücker, G., Ramos-Cormenzana, A., Hoyos, S.G., Neugebauer, M., Ossenkop, T., 1996. Problems of identifying phenolic compounds during the microbial degradation of olive mill wastewater. Int. Biodeterior. Biodegrad. 38, 277-282.
Mekki, A., Dhouib, A., Sayadi, S., 2006. Changes in microbial and soil properties following amendment with treated and untreated olive mill wastewater. Microbiol. Res. 161, 93-101.
Mantzavinos, D., Kalogerakis, N., 2005. Treatment of olive mill effluents. Part I. Organic matter degradation by chemical and biological processes-an overview. Environ. Int. 31, 289-295.
Niaounakis, M., Halvadakis, C.P., 2006. Olive Processing Waste Management: Literature Review and Patent Survey, second ed. Elsevier, Amsterdam, The Netherlands, pp. 200-202.
Otles, S., Selek, I., 2012. Treatment of olive mill wastewater and the use of polyphenols obtained after treatment. Int. J. Food Stud. 1, 85-100.
Papadelli, M., Roussis, A., Papadopoulou, K., Venieraki, A., Chatzipavlidis, I., Katinakis, P., Balis, K., 1996. Biochemical and molecular characterization of an Azobacter vinelandii strain with respect to its ability to grow and fix nitrogen in olive mill wastewater. Int. Biodeterior. Biodegrad. 38, 179-181.
Piotrowska, A., Iamarino, G., Rao, M.A., Gianfreda, L., 2006. Short-term effect of olive mill wastewater (OMW) on chemical and biochemical properties of a semi-arid Mediterranean soil. Soil. Biol. Biochem. 38, 600-610.
Piperidou, C., Cahidou, C., Stalikas, C., Soulti, K., Pilidis, G., Balis, C., 2000. Bioremediation of olive mill wastewater: chemical alterations induced by Azobacter vinelandii. J. Agric. Food Chem. 48, 1941-1948.
Ramos-Cormenzana, A., Juárez-Jiménez, B., Garcia-Pareja, M.P., 1996. Antimicrobial activity of olive mill wastewaters (alpechin) and biotransformed olive oil mill wastewater. Olive oil processes and by-products recycling. Int. Biodeterior. Biodegrad. 38, 283-290.
Rozzi, A., Malpei, F., 1996. Treatment and disposal of olive mill effluents. Int. Biodeterior. Biodegrad. 38 (3-4), 135-144.
Taccari, M., Ciani, M., 2011. Use of Pichia fermentans and Candida sp. strains for the biological treatment of stored olive mill wastewater. Biotechnol. Lett. 33, 2385-2390.
Taccari, M., Stringini, M., Comitini, F., Ciani, M., 2009. Effect of Phanerochaete chrysosporium inoculation during maturation of co-composted agricultural wastes mixed with olive mill wastewater. Waste Manag. 29, 1615-1621.

Il gruppo di ricerca dell’Università Politecnica delle Marche
La foto di apertura è di Luigi Caricato